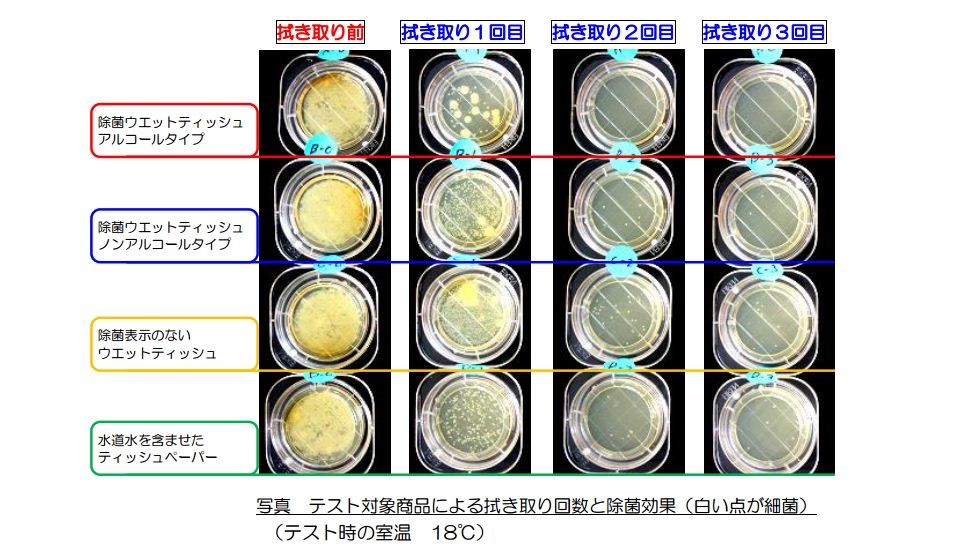

菌 イラスト リアル
- Pinterest で まんぷくまる くいしんぼう さんのボード「鹿イラスト」を見てみましょう。。「鹿, イラスト, バンビ」のアイデアをもっと見てみましょう。.
菌 イラスト リアル. 2月12日はペニシリンの日だそうです。イギリスのオックスフォード大学附属病院が、世界で初めてペニシリンの臨床実験に成功した日なんだとか。 それにちなんで、グラム染色で分類して抗菌薬と対応させていきましょう。 グラム陽性菌とグラム陰性菌の構造の違いと抗菌薬 グラム染色. 三次元図面の結核菌、大腸菌、サルモネラ、エンテロバクター属、シトロバクター属、腸内細菌、腸内細菌、微生物のリアルなイラスト の写真素材をダウンロード。低価格でご購入いただけます。 Image. 感染症対策セット_04_青イラスト 「予防対策実施中」 このイラストをダウンロードする 予防対策実施中4点セットa4サイズイラスト.
おならをする男性のフリーイラスト フリーイラスト クラシック 腸 イラスト 無料 無料イラスト 腸 パブリックドメインq. 白癬菌 完治までのポイントは? 貧血の原因とは?種類と治療法を解説 大腸がんの薬物療法に必要な「患者力」とは?. 透明なpet素材に印刷された、リアルな植物のシールです。 透明なので、貼る紙の色や装飾を活かした使い方ができます。 1パックに種類の異なるデザインのシールが、2枚ずつ入っています(合計40枚)。 全部で6種類あります。 a.
虫歯菌イラストなら 小学校 幼稚園向け 保育園向けのかわいい無料. 細菌、細菌のモデル、微生物は、大腸菌のリアルなイラストのデジタル イラストレーション大腸菌、クレブシエラ属、サルモネラ、クロストリジウム属、緑膿菌、赤痢菌、レジオネラ の写真素材をダウンロード。低価格でご購入いただけます。 Image. もやしもん イラスト 納豆菌 bナットウ 希望は残っているよ.
虫歯の痛そうなイラスト 無料イラストのimt 商用ok 加工ok. トップコレクション もやしもん イラスト もやしもん 怒狸庵blog もやしもん イラスト オリゼー ファイナルエディション 希望は残って. 無料でお使いいただける、食育にまつわるイラスト集です。 給食だよりや保健だよりなどの印刷物に、ぜひお役立てください。 イラスト素材集|明治の食育|株式会社 明治 - Meiji Co., Ltd.
〒104-0032 東京都中央区八丁堀4-2-1東京リアル宝町ビル4f tel:03-4405-4106(講習会受付センター). 時計文字盤の中にアナログ針と時刻文字が書かれたイラストをダウンロードできます。時刻は5分刻みで全ての画像が揃っています。画像サイズは、1,000 x 1,000 ピクセル。時間帯を選ぶ毎時00分毎時30分1時台2時台3時台4時台5時台6時. 1.リアルタイムpcrとは リアルタイムpcrとは、pcrによる増幅産物をリアルタイムでモニタリングすることで、増幅率に基づいて 初期 の dnaの定量 ができる 定量pcr のことです。 リアルタイムrt-pcr法は、 mrnaの発現量を定量的に測定 する目的でよく使用されています。.
合法全裸 黒髪ロング 天狗 全裸 カラモネラ菌 東方動物園 年08月15日 10:57:55. - この作品 「sbr」 は 「ジョジョの奇妙な冒険」「sbr」 等のタグがつけられた「紫杉菌菌」さんの漫画です。 「不自量力的参了个插图本…完整的图画起来果然很吃力啊!.

歯医者 いらすとあ Part 3

悪玉菌アイコン Csai Png 無料イラスト素材 素材ラボ

緑膿菌 Wikipedia
菌 イラスト リアル のギャラリー

細菌の写真素材 人気順 フォトライブラリー Photolibrary
ロイヤリティフリー ウイルス 擬人 化 壁紙とイラスト画像

緑膿菌菌 モデル 細菌の微生物のリアルなイラスト の写真素材 画像素材 Image
ウイルス3d微生物が単離されるコロナウイルス菌のリアルなクローズアップモデル アレルギーのベクターアート素材や画像を多数ご用意 Istock

無料イラスト アルコール除菌ジェル

リアルクローズ イラストレーション ファッションを魅力的に描くクリエイターズファイル パイ インターナショナル 本 通販 Amazon

医者のはなしがよくわかる 診察室のツボ ピロリ菌 感染症で発症するガンとは アサ芸プラス

森の中の宝石みたい キノコでもバクテリアでもない生き物 変形菌 の写真集が美しい ねとらぼ
39 064点のウイルスイラスト素材 Getty Images

手 シルエット イラストの無料ダウンロードサイト シルエットac

結核菌 の写真素材 イラスト素材 アマナイメージズ
暗い背景に新しいコロナウイルスの概念セキュリティと脅威の検出の概念コロナウイルス菌のリアルなクローズアップモデル地球のウイルス感染の脅威 アレルギーのベクターアート素材や画像を多数ご用意 Istock

子どもが描いたイラストをフォトショップでリアルに再現したらこうなりました 年7月23日 エキサイトニュース

ばい菌の写真素材 人気順 フォトライブラリー Photolibrary

アート 美しい菌の世界を Naver まとめ

森の中の宝石みたい キノコでもバクテリアでもない生き物 変形菌 の写真集が美しい ねとらぼ

日本の国菌 オリゼー って何だ 和食をささえるふしぎなカビを探る児童向けノンフィクション 発売 株式会社 岩崎書店のプレスリリース

三次元図面の結核菌 大腸菌 サルモネラ エンテロバクター属 シトロバクター属 腸内細菌 腸内細菌 微生物のリアルなイラスト の写真素材 画像素材 Image

感染不安が生んだ 消毒おばさん 家から出ないおじさん の大迷惑 マネーポストweb Yahoo ニュース

ゴキブリ専門 70種の無料イラスト素材を配布スタート 擬人化キャラやリアルな 株式会社シンクラフト プレスリリース

菌のイラスト素材
動物グッズ リアル動物園ぬいぐるみbig 2 30個入 Purrworld Com

紫一蒸菌 イラスト アニメ 太宰治 中原中也

あなたが作ったパンが商品化されるかも リアルいーすとけんコンテスト 開催 いーすとけん パンがいる生活 Kodama 幻冬舎plus

レジオネラ ニューモフィラ菌 の写真素材 イラスト素材 アマナイメージズ

白い背景の棒状菌の 3 D イラストレーション 微生物のリアルなイラスト の写真素材 画像素材 Image

会員様限定 Off 除菌スプレー ノンアルコール 日本製 ウイルス対策 除去 Jokinコンプリート 除菌コンプリート 280ml 2本 消臭スプレー 手 肌にやさしい 化粧品成分 土日祝も16時まで即日発送 火曜以外 の通販 生活用品 の正規取扱店 セレクトショップreal
ゆうメール利用不可 社会のリアル とつきあうセット 全6冊 太郎次郎社エディタス Www Purrworld Com
Dtuifuvoerqx1m

第二号怪人 ノゲローン 怪人と大幸薬品と除菌と薬品と手洗いのイラスト イラストレーター検索 Illustrator E Space

女性の足 パンプス 内部透視 Perming3dcg リアルイラスト素材のイラスト素材
かわいい 犬 秋田犬 いぬ ドッグ の ちょっと リアル イラスト 商用フリー 無料 のイラスト素材なら イラストマンション

介護職なら知っておくべき 新型コロナ インフルなど感染症予防の基礎知識 株式会社ケアリッツ アンド パートナーズ

健康 イラスト無料

コロナに勝つ ニッポンの会社 発熱外来テント を供給 除菌消毒サービスを24時間提供 J Cast 会社ウォッチ

はみがきしない子はだれだ Let S Brush Your Teeth Youtube

虫歯菌に場所をとられる歯のイラスト素材

アルコール除菌をリアルに体験 インフルエンザ感染の予防策を楽しく学びました Hapiku ハピク 食育

細菌 細菌のモデル 微生物は 大腸菌のリアルなイラストのデジタル イラストレーション大腸菌 クレブシエラ属 サルモネラ クロストリジウム属 緑膿菌 赤痢 菌 レジオネラ の写真素材 画像素材 Image

髄膜炎菌 の写真素材 イラスト素材 アマナイメージズ
除菌 商品に消費者は過度の期待 退治できない ばい菌 だってある J Cast ニュース 全文表示

黒の背景 細菌のモデル 微生物 微生物 ソヴィチッレと鞭毛菌を棒状のリアルなイラストで分離された大腸菌 の写真素材 画像素材 Image

Tsubasa アークナイツ始めました さて 遅くなりましたが本日は全国の歯フェチの皆さんお待ちかねの虫歯の日を記念して新作の虫歯絵を公開させて頂きます 幼少の頃に抱いていた 児童書の虫歯の絵がもっとリアルだったなら という長年の夢を実現させまし

腸内フローラって 腸のどこにいるの 今さら聞けない 大腸 腸内フローラ基礎知識 前編 Happy Plus One ハピプラワン

白い背景の棒状菌の 3 D イラストレーション 微生物のリアルなイラスト の写真素材 画像素材 Image
リアルな生物微生物組成 アイコンのベクターアート素材や画像を多数ご用意 Istock

プロバイオティクスとプレバイオティクス 通常のグラム陽性嫌気性菌叢背景 明るい緑の青の色で編集可能なベクターイラスト リアルなスタイル 医療 医療 科学のコンセプト のベクター画像素材 ロイヤリティフリー

ウイルス リアルタッチ イラスト素材 フォトライブラリー Photolibrary

楽天ブックス 美しい変形菌 高野丈 本
コロナウイルス細胞のリアルなイラスト 3dのストックフォトや画像を多数ご用意 Istock
4 871点の消毒イラスト素材 Getty Images

ウイルスの写真素材 写真素材なら 写真ac 無料 フリー ダウンロードok

胃の中の菌のイラスト ピロリ菌 胃がん のイラスト素材

ウィルス マスク 予防の無料イラスト イラストボックス

外出禁止の国が実践する 非常時生活 のリアル ほしいのは つかれない家族 東洋経済オンライン 経済ニュースの新基準

細菌 カラフルな背景を細菌のモデル 微生物 微生物 結核を引き起こす細菌のリアルなイラストで結核菌の顕微鏡ビュー の写真素材 画像素材 Image

虫歯菌イラスト Csai Png 無料イラスト素材 素材ラボ

ウィルス マスク 予防の無料イラスト イラストボックス

イラストレーター 斉藤ヨーコ 料理イラスト リアルイラスト イラストルポ イラストマップ 67
スパイラルバクテリアリアルベクターイラスト 3dのベクターアート素材や画像を多数ご用意 Istock

マスクイラスト 無料イラストなら イラストac

ウイルスの写真素材 写真素材なら 写真ac 無料 フリー ダウンロードok

イラストレーター 斉藤ヨーコ 料理イラスト リアルイラスト イラストルポ イラストマップ

イラスト のブログ記事一覧 きの子の粘菌生活

煮熟男爵 搬運菌 17 11 23 ペン画 絵 絵日記 日記 イラスト クリーンカラーリアルブラッシュ スプラトゥーン2 Old Follow Art Arts Artists Artwork Draw Drawing Paint Painting Paintings Illustration Myart Artistsontwitter

菌のイラスト素材

無料多数 新型コロナウイルスに関するイラスト素材サイト11選 Workship Magazine ワークシップマガジン

病原菌 の画像 写真素材 ベクター画像 Shutterstock

納豆 イラスト イラレでリアルより美しく トッピング診断 納豆の作り方 納豆菌 栄養

学校に持っていくフック付きハンドタオルのイラストお手拭き フック タオル ハンカチ 保育園 幼稚園 小学校 学校 清潔 持ち物 除菌 クローバー 三つ葉 模様イラスト No フリー素材 無料イラストなら イラストac フリー素材 イラスト イラスト

白背景 細菌のモデル 微生物 微生物 ソヴィチッレと鞭毛菌を棒状のリアルなイラストで分離された大腸菌 の写真素材 画像素材 Image

無料イラスト 除菌セット
リアルなウイルス細菌および感染細菌細胞微生物学オブジェクトは白色に分離された顕微鏡で目に見えるベクター桿菌 3dのベクターアート素材や画像を多数ご用意 Istock

ハエイラスト No 8698 無料イラストなら イラストac

菌のイラスト素材

虫歯菌イラスト Csai Png 無料イラスト素材 素材ラボ

結城蛍のゴスロリ姿を完全再現 もやしもん リアル等身フィギュアが登場 Gigazine

白い背景の棒状菌の 3 D イラストレーション 微生物のリアルなイラスト の写真素材 画像素材 Image

第三号怪人 テアサッキー 怪人と大幸薬品と除菌と薬品と手洗いのイラスト イラストレーター検索 Illustrator E Space

Owx57fmwjtkfpm

無料多数 新型コロナウイルスに関するイラスト素材サイト11選 Workship Magazine ワークシップマガジン

納豆 イラスト イラレでリアルより美しく トッピング診断 納豆の作り方 納豆菌 栄養

佐藤正久 Auf Twitter まだまだ募集中 リアル バーチャル選挙事務所に飾らせてもらっています 応援イラスト 写真 佐藤まさひさ イラスト をつけてツイート みんなのミリタリー写真 T Co 3toersk3ne ネット為書き T Co

菌に還る刻がきた 14年01月26日のイラストのボケ ボケて Bokete

除菌 イラスト みさとぷりんと イラスト 背景素材

Amazon Co Jp 写真加工で作る風景イラスト 神技作画シリーズ さけハラス 本

Amazon Co Jp 写真加工で作る風景イラスト 神技作画シリーズ さけハラス 本

三次元図面の結核菌 大腸菌 サルモネラ エンテロバクター属 シトロバクター属 腸内細菌 腸内細菌 微生物のリアルなイラスト の写真素材 画像素材 Image

リアルにのtwitterイラスト検索結果 古い順

胃に潜むピロリ菌のフリーイラスト素材

ウイルスから子供を守る 肌に優しいお出かけ用99 9 光触媒除菌スプレー 自分専用のハンドソープが登場 人気イラストレーターつむぱぱイラスト のムービーも公開中 株式会社ドリームズのプレスリリース

新型コロナウイルスのリアルなイラスト 無料イラスト素材 素材ラボ

アスリートの便は茶色のダイヤ 腸内から 新種の菌 発見 感染症予防や健康維持に注目集まる Abema Times

白い背景の棒状菌の 3 D イラストレーション 微生物のリアルなイラスト の写真素材 画像素材 Image

日本の国菌 オリゼー って何だ 和食をささえるふしぎなカビを探る児童向けノンフィクション 発売 株式会社 岩崎書店のプレスリリース

Ai1wmcibepgpvm

ウィルス マスク 予防の無料イラスト イラストボックス